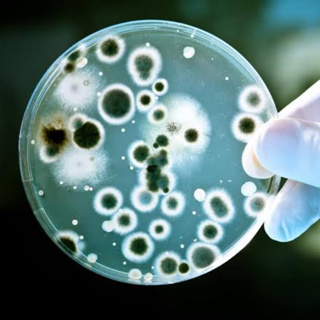
How first antibiotic was discovered? How antibiotics works? What are Superbugs?

Fun Facts About the Periodic Table
Fun Facts About the Periodic TableThere are 118 elements in the periodic table – each one with unique properties that make up everything around us.The first element is Hydrogen – it's the most abundan...
3 Nov 20242min

Kitabe: Best Science Books 1 Must have to change their life and understanding of Science 🧬 in Hindi
Vigyan ki Kitabein: Kitabe Best Science Books 1 Must have to change their life and understanding of science 🧬 Aap in sabhi kitabon ke bare me niche di gae link se jankari le sakte hain https://www.ch...
3 Nov 20244min

Discovering Fascinating Facts with "Interesting Facts About All Elements of the Periodic Table"
In this special episode, we delve into the creation of "Interesting Facts About All Elements of the Periodic Table," a captivating book designed to ignite curiosity and bring the world of elements to ...
25 Okt 20245min

Lifesaving Power of Vaccines: Types and Must-Have Immunizations for Adults
Lifesaving Power of Vaccines: Types and Must-Have Immunizations for AdultsVaccines are biological preparations designed to provide immunity to a specific disease. They stimulate the body's immune syst...
23 Okt 202415min

Pasteurisation | Technique to keep food safe & last longer | Process of Pasteurization | its Science
Pasteurisation | Technique to keep food safe & last longer | Process of Pasteurisation | its ScienceLearn more about Science and Chemistry ⚛️ at our website www.ChemistryNotesInfo.comJoin us at Whatsa...
13 Okt 20248min
How first antibiotic was discovered? How antibiotics works? What are Superbugs?
In this LEARN SCIENCE AND CHEMISTRY podcast we will learn about-How antibiotic was discovered? How antibiotics works? What are Superbugs?www.ChemistryNotesInfo.comJoin us at WhatsApp
12 Okt 20246min

How Vaccine 💉 works, How virus 🦠 infect us, How our immune system works 🛡️
How Vaccine 💉 works, How virus 🦠 infect us, How our immune system works 🛡️Stay Healthy Stay Happy #virus #vaccine #immunesystem #immunity #howvirusworks #howvaccineworks #howimmunesystemworks #scie...
9 Okt 202413min

Why Science is Important?
In this podcast we will get answer of question- Why Science is important ? https://www.chemistrynotesinfo.com/search/label/Science%20TALK
8 Okt 20246min






















